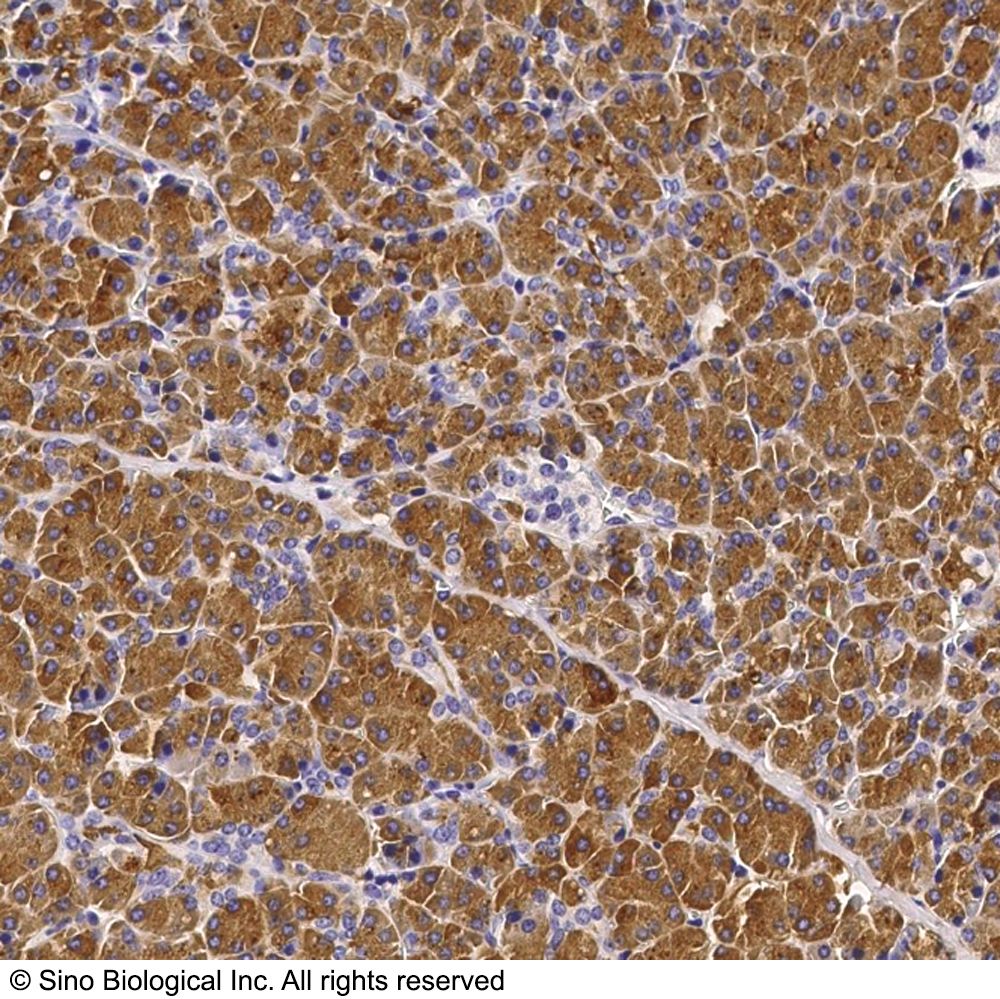
产品封面图

研选同类产品更多 >
万千商家帮你免费找货
0 人在求购买到急需产品
- 详细信息
- 用户评价
- 文献和实验
- 技术资料
- 免疫原:
Recombinant Human CTRC / chymotrypsin C protein (Catalog#11456-H08H)
- 亚型:
Rabbit IgG
- 形态:
液体
- 保存条件:
在-20℃ to -80℃
- 克隆性:
PAb
- 适应物种:
兔
- 保质期:
12个月
- 抗原来源:
11456-H08H
- 目录编号:
11456-T24
- 级别:
免疫学试剂
- 库存:
99
- 供应商:
北京义翘神州科技股份有限公司
- 宿主:
Rabbit
- 应用范围:
ELISA,IHC-P
- 浓度:
ELISA: 1:5000-1:10000;IHC-P: 1:500-1:2000
- 靶点:
CTRC
- 抗体英文名:
CTRC / chymotrypsin C Antibody, Rabbit PAb, Antigen Affinity Purified
- 抗体名:
CTRC / chymotrypsin C 兔多抗
- 规格:
100 µL
CTRC / chymotrypsin C 兔多抗(产品说明)
抗体种属:Human
抗体靶点:CTRC
抗体应用:ELISA,IHC-P
抗原货号:11456-H08H
抗原描述:Recombinant Human CTRC / chymotrypsin C protein (Catalog#11456-H08H)
抗体宿主:Rabbit
抗体Ig类型:Rabbit IgG
抗体纯化方法:Protein A & Antigen Affinity
抗体制备:Produced in rabbits immunized with purified, recombinant Human CTRC / chymotrypsin C (rh CTRC / chymotrypsin C; Catalog#11456-H08H; Q99895; Met1-Leu268). CTRC / chymotrypsin C specific IgG was purified by Human CTRC / chymotrypsin C affinity chromatography.
抗体特异性:Human CTRC / chymotrypsin C
抗体保存:This antibody can be stored at 2℃-8℃ for one month without detectable loss of activity. Antibody products are stable for twelve months from date of receipt when stored at -20℃ to -80℃. Preservative-Free. Avoid repeated freeze-thaw cycles.
风险提示:丁香通仅作为第三方平台,为商家信息发布提供平台空间。用户咨询产品时请注意保护个人信息及财产安全,合理判断,谨慎选购商品,商家和用户对交易行为负责。对于医疗器械类产品,请先查证核实企业经营资质和医疗器械产品注册证情况。
用户评价
暂无用户评价
文献和实验1, Huang L, et al. Commitment and oncogene-induced plasticity of human stem cell-derived pancreatic acinar and ductal organoids.Cell stem cell, PubMed ID: 33915081
Development of techniques for primary culture of C. elegans embryonic neurons
. The chambers were covered in aluminum foil to protect the cells from light and placed in the same 20'C incubator used for growing worms. Cells were viewed with Nomarski optics and a 100x oil-immersion objective lens. 24 x 50 mm coverslips
是去垢的作用; PMSF PMSF即Phenylmethanesulfonyl fluoride,也称Phenylmethylsulfonyl fluoride或α-Toluenesulfonyl fluoride。中文名为苯甲基磺酰氟。分子式为C7H7FO2S,分子量为174.19。可抑制丝氨酸蛋白酶例如胰蛋白酶(trypsin)和胰凝乳蛋白酶(chymotrypsin),也可抑制半胱氨酸蛋白酶和乙酰胆碱酯酶。有效浓度为0.1-1mM。难溶于水,且在水溶液中非常不稳
Two dimensional peptide mapping
(enough to cover the piece of membrane). Start the digestion by adding 10 micrograms trypsin or chymotrypsin (Stock is 1 milligram/ml in 0.05 M NH4HCO3 stored at -70°C) . Mix by pipetting up and down and incubate at 37°C for 2 hr. 5. Vortex the sample
技术资料暂无技术资料 索取技术资料